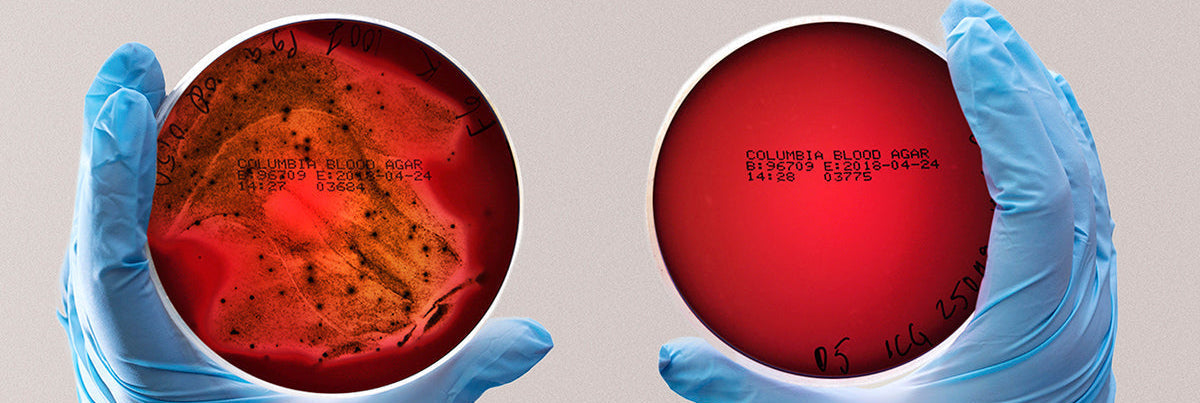
Porphyromonas Gingivalis plates

Wat zegt de wetenschap
Wat is residuele tandplak?
Dunne, hardnekkige biofilm die achterblijft na poetsen vooral langs de tandvleesrand, tussen tanden en rond beugels/implantaten.
Ze veroorzaakt tandvleesonsteking (gingivitis), cariës en kan uitgroeien tot parodontitis met botverlies, peri-implantitis en halitose (slechts adem).
Chronische mondontsteking verhoogt bovendien de systemische ontstekingslast en hangt samen met diabetesontregeling en cardiovasculaire risico’s.
*De beelden tonen dezelfde situatie onder verschillende belichtingen; dit is geen “voor/na”-vergelijking en toont geen behandelresultaat.

Normaal licht

Nabij-infrarood licht
Gepubliceerde Lumoral-gerelateerde studies en hun kernbevindingen
"Een klinische studie is niet zomaar één marathon; het is een reeks marathons die telkens opnieuw gelopen worden in een iets ander landschap. Zelfs als je één doel bereikt, kunnen er nog meerdere trajecten volgen – en wellicht ook nieuwe die zich aandienen."
– Mikko Kylmänen, Onderzoekscoördinator, Koite Health Ltd
Lees meer over het Lumoral-onderzoek op lumoralpro.com.
⚠️Deze rubriek bundelt peer-reviewde publicaties over Lumoral en gerelateerde thema’s. Ze omvat klinische studies (bv. RCT, cohort), peer-reviewde reviews/opinieartikelen en—indien in een peer-reviewd tijdschrift gepubliceerd—pilootstudies en casus(reeksen).
⚠️De evidentiewaarde varieert: klinische studies bieden doorgaans sterker bewijs dan casus/piloot of opinie. Elk item is duidelijk gelabeld.
⚠️De inhoud is informatief en vervangt geen diagnose, behandeling of persoonlijk advies; overleg steeds met uw tandarts/mondhygiënist.
Probeer Lumoral 30 dagen risicovrij🧪Dagelijkse Lumoral-therapie houdt bacteriën onder controle en voorkomt dat ze zich aanpassen
In-vitro laboratoriumonderzoek, Nikinmaa et el. 2020
Probleem: Streptococcus mutans is een belangrijke bacterie die tandbederf veroorzaakt. Sommige bacteriën kunnen zich aanpassen aan behandelingen, waardoor deze minder effectief worden.
Wat onderzocht? Onderzocht werd of dagelijks gebruik van dual-light foto-dynamische therapie (Lumoral-techniek) biofilm kan blijven verminderen én kan voorkomen dat S. mutans zich aanpast. Dit werd vergeleken met alleen rood licht, alleen blauw licht en geen behandeling.
Resultaat: Dagelijks Lumoral-gebruik verminderde de bacteriepopulatie in de biofilm blijvend en voorkwam dat S. mutans zich aanpaste. Bij alleen rood of blauw licht trad er wel gewenning op en nam het effect af. Dit laat zien dat Lumoral ook op lange termijn krachtig kan blijven tegen cariësbacteriën.
- ↓↓↓ Streptococcus Mutans
- ↓ Bacteriëledoptatie
🧪Lumoral helpt effectief tandbacteriën en biofilm te verwijderen
In-vitro laboratoriumonderzoek, Hentilä et el. 2021
Probleem: Streptococcus oralis is een gewone mondbacterie, maar bij overgroei kan die bijdragen aan tandvleesontsteking en ernstige infecties veroorzaken. De biofilm-vorm die deze bacterie vormt, is bijzonder moeilijk te verwijderen.
Wat onderzocht? In het laboratorium keken onderzoekers of dual-light fotodynamische therapie (Lumoral-techniek) biofilm van S. oralis volledig kon elimineren, vergeleken met alleen blauw licht, alleen indocyaninegroen of geen behandeling.
Resultaat: Lumoral verwijderde de S. oralis-biofilms volledig (er werden geen overlevende bacteriekolonies gevonden), terwijl de andere behandelingen veel minder effectief waren. Dit toont aan dat Lumoral ook hardnekkige bacteriën die tandvleesontstekingen kunnen veroorzaken, kan aanpakken. Het wijst op een zeer sterke ontsmettende werking die nuttig kan zijn om infectierisico’s te beperken bij patiënten met orale mucositis (pijnlijke ontsteking en beschadiging van het mondslijmvlies die vaak voorkomt bij mensen die een kankerbehandeling ondergaan, zoals chemotherapie of radiotherapie).
- ↓↓↓ Streptococcus Oralis
🧪Dagelijkse Lumoral-behandeling remt schadelijke bacteriën zoals Staphylococcus aureus
Laboratoriumonderzoek (In vitro), Nikinmaa et el. 2021
Probleem: Staphylococcus aureus is een bacterie die soms in de mond voorkomt en berucht is omdat ze moeilijk volledig te verwijderen is. Ze kan ook wondinfecties veroorzaken, zeker bij mensen met een verzwakt immuunsysteem.
Wat onderzocht? In het laboratorium werden bacteriekolonies van S. aureus herhaaldelijk blootgesteld aan Lumoral (dual-light fotodynamische therapie met indocyaninegroen). Er werd gekeken of de bacterie zich kon aanpassen en ongevoelig worden voor de behandeling.
Resultaat: Dagelijks gebruik van Lumoral doodde een groot deel van de bacteriën bij elke behandeling en voorkwam dat de bacterie zich kon aanpassen of resistent werd. Dit suggereert dat Lumoral ook bij herhaald gebruik effectief blijft tegen hardnekkige bacteriën zoals S. aureus.
- ↓↓↓ Stafylococcus Aureus
🧪🔀Lumorinse met speciale kleurstof (ICG - Indocyaninegroen) en dual LED licht vermindert tandplak zichtbaar
Gerandomiseerde split-mouth klinische studie met 15 deelnemers, 2 weken, Ninikmaa et el. (2021)
Probleem: Tandplak is de belangrijkste oorzaak van gaatjes en tandvleesontstekingen.
Zelfs bij goed poetsen en flossen blijven bacteriën achter, vooral op moeilijk bereikbare plekken.
Wat onderzocht? De ene helft van de mond kreeg naast normale mondhygiëne ook dagelijks Lumoral-behandeling; de andere helft alleen normale mondhygiëne. De hoeveelheid tandplak werd gemeten met de Visible Plaque Index (VPI).
Resultaat: De Lumoral-behandelde zijde had na 2 weken –51% minder tandplak (VPI) ten opzichte van de start, vergeleken met –38% in de zijde met normale mondhygiëne. Dit bevestigt dat Lumoral helpt om tandplak te verminderen, zelfs op lastig bereikbare plaatsen.
- ↓↓↓ Hoeveelheid vroege vorming van tandplak
- ↓↓↓ MMP8-concentratie
- → (geen effect) Bacteriële diversiteit
- ↓↓↓ Streptokokkenal soorten
- ↓↓↓ Actinomyces soorten
- ↓ Capnocytophaga soorten
- ↓↓↓ Rothia soorten
👥📝Herhaald thuisgebruik van Lumoral kan tandplak, ontstekingen en schadelijke enzymen rond implantaten verminderen
First in human, pilotstudie met 7 deelnemers (65 - 89), 4 weken, Lähteenmäki et el.2022
Probleem: Ontsteking rond implantaten (peri-implantitis) kan leiden tot verlies van bot en uiteindelijk het implantaat.
Het is vaak moeilijk om deze ontsteking volledig onder controle te krijgen met alleen mechanische reiniging en zelfzorg.
Onderzoek:Vergelijking tussen verbeterde zelfzorg alleen en verbeterde zelfzorg + dagelijks Lumoral-gebruik (eerste 2 weken 1× per dag, daarna 2 weken 2× per dag).
Resultaat:In de Lumoral-groep daalde de bloeding rond implantaten duidelijk sterker dan in de controlegroep. Ook werd een grotere daling van aMMP-8 gemeten, wat wijst op minder actieve weefselafbraak. De hoeveelheid tandplak nam in beide groepen af, maar de verbetering in bloeding en ontstekingswaarden was sterker in de Lumoral-groep.
- ↑ Mondhygiëne
- ↓↓ Bloeding bij sonderen (BOP)
- ↓↓ Hoeveelheid tandplak (VPI)
- ↓↓ aMMP8-niveaus
- ↓ Parodontale pocketdiepte (PPD)
👥📝Dagelijks Lumoral-gebruik ondersteunt tandvleesgezondheid bij parodontitis
Casus rapport, 1 patiënt (78), 2 maanden, Trujiilo et el. 2022
Probleem: Hardnekkige tandvleesontsteking (parodontitis) kan blijven bestaan ondanks professionele behandeling, met risico op tandverlies.
Wat onderzocht? Bij één patiënt werd gedurende twee maanden dagelijks Lumoral toegepast als aanvulling op bestaande mondhygiëne. Ontstekingsparameters zoals bloeding (BOP), tandplak (VPI), pocketdiepte (PPD) en ontstekingsmarker aMMP-8 werden gemeten.
Resultaat: Na 2 maanden waren er duidelijke verbeteringen: minder bloedend tandvlees (BOP), minder tandplak (VPI) en minder diepe pockets (PPD). Ook waren er tekenen van herstel van het tandvlees en een gezondere mondomgeving.
- ↓↓↓ Hoeveelheid tandplak (VPI)
- ↓↓↓ Bloeding bij sonderen (BOP)
- ↓ Aantal geïnfecteerde diepe parodontale pockets
🔀Thuisgebruik van Lumoral als aanvulling op tandvleesbehandeling toont betere resultaten na 3 maanden
Gerandomiseerd, gecontroleerd klinisch onderzoek (RCT) met 59 deelnemers, 3 maanden (interim resultaten), Pakarinen et el. (2022)
Probleem: Chronische tandvleesontsteking (parodontitis) kan, zelfs na professionele reiniging, blijven bestaan. Dit zorgt voor bloedend tandvlees, terugtrekkend tandvlees en op termijn verlies van tanden.
Wat onderzocht? Vergelijking van standaard tandvleesbehandeling (niet-chirurgische parodontale therapie) alleen met dezelfde behandeling + dagelijks Lumoral-gebruik. Bij sommige deelnemers werd een split-mouth-opzet gebruikt (één helft van de mond behandeld met Lumoral, de andere helft niet).
Resultaatl: Beide groepen verbeterden, maar de Lumoral-groep had extra winst:
- ↑↑↑ Mondhygiëne
- ↓ Hoeveelheid tandplak (VPI)
- ↓↓↓ Aantal diepe parodontale pockets
- ↓↓↓ Ontstoken diepe parodontale pockets
Ook werd een duidelijke daling gezien van de ontstekingsmarker aMMP-8 in het mondvocht, wat wijst op minder actieve weefselafbraak.
🔀Lumoral versterkt de behandeling van ontstekingen rond implantaten
Gerandomiseerd, gecontroleerd klinisch onderzoek, 6 maanden, Lähteenmäki et el. 2024
Probleem: Ontsteking rond tandimplantaten (peri-implantitis en mucositis) veroorzaakt rood, gezwollen en bloedend tandvlees, wat kan leiden tot verlies van het implantaat. Standaard tandartsbehandeling haalt niet altijd alle bacteriën weg.
Wat onderzocht? Standaard professionele reiniging werd vergeleken met dezelfde behandeling aangevuld met thuisgebruik van Lumoral (2× per week).
Resultaat: De Lumoral-groep liet na 6 maanden minder bloedend tandvlees (BOP – Bleeding on Probing) zien, minder diepe pockets (PPD – Probing Pocket Depth) en lagere waarden van aMMP-8 (een ontstekingsmarker die vrijkomt bij actieve weefselafbraak).
- ↓↓↓ Bloeden bij sonderen (BOP)
- ↓↓↓ aMMP-8 niveaus
- ↓ Hoeveelheid tandplak (VPI) in beide groepen
🛡️📄Vroegtijdige opsporing en aanvullende thuisbehandeling bij tandvleesontsteking: aMMP-8-test en Lumoral-therapie
Peer-reviewd opinie/overzicht (observatiegegevens, geen RCT), verschenen in Dentistry Journal, Nur Rahman Ahmad Seno Aji en el. (2025)
Probleem: Parodontitis en peri-implantitis veroorzaken vaak stille, aanhoudende schade aan tandvlees en kaakbot. Klassieke controles (pocketdiepte, bloeding) tonen problemen meestal pas in een later stadium. Vroegtijdige detectie en gerichte ondersteuning kunnen daardoor een verschil maken.
Wat is de aMMP-8 point-of-care test (POCT)? aMMP-8 is een actieve ontstekingsmarker die vrijkomt bij weefselafbraak rond tanden en implantaten. Met een snelle speekseltestest kan de zorgverlener zien of er actieve ontsteking bezig is. In het artikel wordt een drempelwaarde rond 20 ng/mL gehanteerd als signaal voor verhoogde risico-activiteit.
Wat is Lumoral-therapie (dual-light aPDT)? Lumoral combineert licht met een extern aangebrachte fotosensitizer (Lumorinse) om tandplak gericht te verstoren. Het is bedoeld als aanvulling op de standaardzorg (poetsen, ragen/flossen en niet-chirurgische parodontale behandeling, NSPT), niet als vervanging. Een voorgesteld mechanisme is een “storm” van reactieve zuurstofdeeltjes die de biofilm en ontstekingsactiviteit aanpakken.
Wat laat het artikel zien (samengevat)? Diagnostiek: met aMMP-8 kun je eerder signaleren of er actieve weefselafbraak plaatsvindt, nog vóór klassieke metingen dat duidelijk maken.
Therapie (observatiegegevens): patiënten die NSPT + Lumoral kregen, haalden vaker het doel BOP < 10% dan NSPT alleen. Daarnaast kunnen 2×PDT/Lumoral en de lingonberry-spoeling (Lingora) verhoogde aMMP-8-waarden (in mondspoeling, GCF, PISF) doen dalen richting gezondere niveaus.
Wat betekent dit voor u/patiënten?
- De aMMP-8-test kan helpen om tijdig in te grijpen wanneer ontsteking actief is.
- Lumoral kan als thuisaanvulling de bacteriële belasting en ontsteking verder verminderen naast poetsen, ragen/flossen en professionele behandeling. Bespreek toepassing en schema met uw tandarts/mondhygiënist.
Belangrijke kanttekeningen: Dit is een peer-reviewd opinie/overzicht: het artikel bundelt en duidt bestaande literatuur (incl. observatieonderzoek), maar is geen nieuwe RCT. De auteurs wijzen op de nood aan grotere, gecontroleerde studies en vermelden belangenconflicten. Gebruik de informatie als aanvulling op professionele richtlijnen.
Lees de publicatie
Overige Lumoral publicaties!
Een scriptie of klinische studie staat nooit op zichzelf. Het is niet één enkel antwoord, maar een stapsteen in een langere reis. Elk onderzoek kijkt vanuit een iets ander perspectief, in een iets andere context, met telkens nieuwe nuances. Samen vormen ze een groeiende puzzel die steeds meer inzicht geeft in hoe Lumoral bijdraagt aan een betere mondgezondheid.
Lees meer over het Lumoral-onderzoek op lumoralpro.com.
⚠️ Let op: de hiernaast besproken publicaties omvatten preprints, scripties en kleinschalige of niet-gecontroleerde onderzoeken.
⚠️ Dergelijke bronnen zijn niet peer-reviewed of kennen een lagere bewijskracht. Resultaten kunnen wijzigen na formele beoordeling of in grotere, gecontroleerde studies. Informatie is uitsluitend bedoeld ter educatie en mag niet worden geïnterpreteerd als klinische aanbeveling.
Doe de mondgezondheidstestLumoral vergeleken met chloorhexidine-mondspoeling bij tandvleesproblemen
Scriptie Latif & Safar 2023
Deze scriptie is een literatuurstudie geen klinisch onderzoek en bevat voorlopig bewijs (de resultaten zijn veelbelovend maar nog niet definitief bevestigd, en vormen geen medische richtlijn) waarin bestaande onderzoeken naar Lumoral en chloorhexidine bij tandvleesproblemen met elkaar werden vergeleken. De auteurs analyseerden publicaties over beide behandelingen en bekeken welke effecten werden gevonden op tandplak, tandvleesontsteking en bijwerkingen.
Probleem: Bij tandvleesontsteking (parodontitis) wordt vaak een chloorhexidine-mondspoeling (CHX) voorgeschreven als extra hulp naast de behandeling bij de tandarts. CHX werkt goed, maar heeft nadelen zoals verkleuring van tanden en een veranderde smaak. Lumoral is een nieuwe methode die met licht en een mondspoeling tandplak aanpakt, zonder de hele mondflora te verstoren.
Wat onderzocht? Twee studenten hebben in hun scriptie bestaande studies vergeleken: werkt Lumoral beter of slechter dan chloorhexidine bij de behandeling van tandvleesproblemen?
Resultaat: Zowel Lumoral als chloorhexidine zorgen voor verbetering van het tandvlees. Lumoral gaf betere resultaten in het verminderen van bloedend tandvlees en diepe pockets.
Chloorhexidine werkte iets beter tegen tandplak, maar heeft meer bijwerkingen (verkleuring, smaakproblemen).
Lumoral werd door gebruikers goed verdragen, met hooguit een licht warm/koud-gevoel of meer speeksel tijdens het gebruik.
Conclusie: Lumoral lijkt een veelbelovend alternatief voor chloorhexidine bij de behandeling van tandvleesproblemen. Het werkt doelgericht op schadelijke bacteriën en wordt beter verdragen door patiënten. Wel is er nog meer onderzoek nodig om de resultaten op lange termijn te bevestigen.
Comfort van het gebruik van het Lumoral-toestel en het gevoel van mondhygiëne bij gezonde volwassenen
Qualitative research met 10 deelnemers Niva, Kulmala & Vakkuri 2024
Probleem:
Bij medische hulpmiddelen is gebruikservaring net zo belangrijk als effectiviteit. Als een toestel ongemakkelijk of lastig is, zal de therapietrouw dalen. Daarom is onderzocht hoe gebruikers Lumoral ervaren.
Wat onderzocht? 10 gezonde volwassenen testten Lumoral. Ze gaven hun mening over: het comfort van het apparaat in de mond, het gevoel van reinheid na gebruik en eventuele ongemakken of bijwerkingen
Resultaat: Deelnemers vonden het toestel comfortabel en gemakkelijk te gebruiken. Ze ervaarden een schoner en frisser gevoel in de mond. Er werden geen noemenswaardige klachten of problemen gemeld.
Conclusie: Dit kleinschalige kwalitatieve onderzoek toont dat Lumoral door gezonde volwassenen goed verdragen wordt en een positieve ervaring geeft. Het is dus een praktische en haalbare aanvulling op dagelijkse mondhygiëne.
Lees artikel (Fins met Engelstalige samenvatting)
Gepubliceerd op Theseus (dienst van de Rectorenconferentie van de Finse Hogescholen Arene)
Effecten van de Lumoral-behandeling op mondzorggewoonten
Vragenlijst Haukka & Kinnunen 2024
Probleem: Veel mensen vinden het lastig om hun mondgezondheid optimaal te onderhouden. Hoewel tandenpoetsen en flossen bekend zijn, blijft tandplak vaak toch aanwezig. Een nieuwe technologie zoals Lumoral kan hierbij helpen, maar de vraag is: verandert het gebruik van Lumoral ook iemands gewoonten en motivatie rond mondzorg?
Wat onderzocht? In deze scriptie werd gekeken hoe Lumoral invloed heeft op de dagelijkse routines en motivatie van gebruikers.
Resultaat: Gebruikers voelden zich meer gemotiveerd om hun mondhygiëne serieus te nemen. Velen merkten dat hun mond schoner en frisser aanvoelde, wat hen stimuleerde om beter te poetsen en te rageren. Lumoral werd gezien als een ondersteunend hulpmiddel dat bestaande gewoonten versterkt in plaats van vervangt.
Conclusie: Het gebruik van Lumoral kan niet alleen de mondgezondheid verbeteren, maar ook de gewoonten en motivatie van mensen positief beïnvloeden. Het helpt patiënten om consequenter en zorgvuldiger met hun dagelijkse mondzorg om te gaan.
Lees artikel (Fins met Engelstalige samenvatting)
Gepubliceerd op Theseus (dienst van de Rectorenconferentie van de Finse Hogescholen Arene)
Effecten van Lumoral op tandplak en tandvleesontsteking
Klinische studie bij 40 personen Sundberg 2024
Probleem: Bij parodontitis (tandvleesontsteking) kan dagelijkse mondhygiëne zoals poetsen en flossen onvoldoende zijn om tandplak en ontsteking onder controle te houden. Er is nood aan aanvullende behandelingen die thuis gebruikt kunnen worden en geen nadelige bijwerkingen hebben.
Wat onderzocht? 40 patiënten (37–77 jaar) met parodontitis stadium II of hoger. Verdeling: controlegroep (alleen standaard mondhygiëne) vs. Lumoral-groep (standaard mondhygiëne + dagelijks gebruik van Lumoral dual-light fotodynamische therapie). Parameters: tandplakindex (VPI), bloeding bij sonderen (BOP) en tandvleesdiepte (PPD).
Resultaat: De Lumoral-groep had duidelijk minder tandplak en minder bloedend tandvlees dan de controlegroep. Ook de tandvleesdiepte verbeterde beter in de Lumoral-groep. Er waren geen ernstige bijwerkingen. Enkele gebruikers merkten lichte warmte of meer speeksel.
Conclusie: Lumoral is een veilig en effectief hulpmiddel naast tandenpoetsen en flossen. Bij patiënten met matige tot ernstige parodontitis kan het ontstekingen verminderen en de tandvleesgezondheid verbeteren.
Gepubliceerd op Helda (University of Helsinki Open Repository)
Effecten van regelmatig thuisgebruik van fotodynamische therapie (Lumoral) op tandplak bij gezonde volwassenen
Universitair onderzoek, Tartu bij 40 personen, Gusseva & Lill 2025
Probleem: Zelfs bij goed poetsen blijft tandplak vaak achter op lastig bereikbare plaatsen. De vraag: helpt Lumoral als extra thuisbehandeling om tandplak verder te verminderen bij gezonde jonge volwassenen met al best goede mondhygiëne?
Wat onderzocht? Deelnemers: 30 gezonde volwassenen (20–25 jaar). Opzet: twee groepen die beiden Lumoral gebruiken, maar op verschillende momenten (A: eerst 2 weken Lumoral → 4 weken pauze; B: eerst 4 weken pauze → daarna 2 weken Lumoral). Vier controlebezoeken met metingen en foto’s. Meting: tandplak via Greene–Vermillion plaque-index (plus foto’s met plaque-indicator). (Microbioom-analyse gepland, maar resultaten nog niet beschikbaar.)
Resultaat:
Na 2 weken Lumoral had 70% minder tandplak; 20% zag geen verandering; 10% meer. Over het hele traject daalde tandplak bij 78,6%.
Wanneer één groep Lumoral gebruikte en de andere nog niet, was er significant minder tandplak in de Lumoral-groep
- middenmeting: p = 0,02 (A < B)
- tweede periode (B start Lumoral): p = 0,01 (B daalt duidelijk)
Gebruikservaring: meestgenoemde punten waren meer speeksel, soms warm aanvoelend mondstuk (pauzeren → verdergaan na afkoelen), en in het algemeen meer motivatie om beter te poetsen. Geen ernstige bijwerkingen.
Conclusie:
Bij gezonde jongeren met al redelijke mondhygiëne zorgt Lumoral meestal voor extra daling van tandplak in twee weken. Het is dus een nuttige aanvulling op poetsen/flossen, al is de winst kleiner dan wat in studies bij parodontitispatiënten is gezien. Dagelijks gebruik lijkt voor deze gezonde doelgroep niet altijd nodig; regelmatig gebruik kan volstaan.
Belangrijke kanttekeningen:
Doelgroep: alleen gezonde 20–25-jarigen; resultaten niet zomaar te vertalen naar oudere of parodontitis-patiënten.
Opzet: beide groepen kregen Lumoral (op verschillende tijdstippen); goed voor vergelijking, maar observer-effect (extra aandacht → beter poetsen) kan meespelen.
Uitkomstmaten: vooral plaque-index en foto’s; 16S-microbioomdata nog niet gerapporteerd.

Het belang van onderzoek
Klinisch onderzoek naar medische hulpmiddelen is van essentieel belang om te garanderen dat deze apparaten veilig, doeltreffend en van de vereiste kwaliteit zijn.
Hoogwaardig klinisch onderzoek, gebaseerd op wetenschappelijke evaluatie, biedt zowel gebruikers als zorgprofessionals vertrouwen in de veiligheid, betrouwbaarheid en effectiviteit van medische technologieën.
Door te investeren in zorgvuldig uitgevoerde studies wordt niet alleen de werking van een product onderbouwd, maar ook bijgedragen aan een betere en meer verantwoorde patiëntenzorg.

Normen vormen de basis van klinisch onderzoek
Internationale normen vormen het fundament van de klinische onderzoeksopzet voor Lumoral. De studies zijn opgezet volgens de richtlijnen van ISO 14155 GCP (Good Clinical Practice voor medische hulpmiddelen) en voldoen aan de vereisten van de **Europese Verordening voor medische hulpmiddelen EU 2017/745 (MDR)*.
Elke klinische studie met Lumoral heeft duidelijk omschreven doelen en onderzoeksvragen: ofwel ter bevestiging van de werking zoals goedgekeurd bij de markttoelating, ofwel om nieuwe toepassingsmogelijkheden van Lumoral te verkennen.
Strikte naleving van deze regelgeving waarborgt niet alleen de wetenschappelijke integriteit van het onderzoek, maar ook de veiligheid en het welzijn van de deelnemers.

Innovatie als drijvende kracht
Het onderzoek rond Lumoral opent nieuwe perspectieven voor de ontwikkeling van mondzorg. Ons bedrijf is trots om via innovatieve oplossingen bij te dragen aan gezondheid en welzijn.
Zowel lopende als afgeronde studies onderstrepen de veelzijdige toepassingen van Lumoral bij het verbeteren van de mondgezondheid in uiteenlopende doelgroepen en aandoeningen.
Deze wetenschappelijk onderbouwde benadering vormt de kern van onze missie: de mondzorg van morgen vandaag al beschikbaar maken.
Het belang van onderzoek
Klinisch onderzoek naar medische hulpmiddelen is van essentieel belang om te garanderen dat deze apparaten veilig, doeltreffend en van de vereiste kwaliteit zijn.
Hoogwaardig klinisch onderzoek, gebaseerd op wetenschappelijke evaluatie, biedt zowel gebruikers als zorgprofessionals vertrouwen in de veiligheid, betrouwbaarheid en effectiviteit van medische technologieën.
Door te investeren in zorgvuldig uitgevoerde studies wordt niet alleen de werking van een product onderbouwd, maar ook bijgedragen aan een betere en meer verantwoorde patiëntenzorg.
Normen vormen de basis van klinisch onderzoek
Internationale normen vormen het fundament van de klinische onderzoeksopzet voor Lumoral. De studies zijn opgezet volgens de richtlijnen van ISO 14155 GCP (Good Clinical Practice voor medische hulpmiddelen) en voldoen aan de vereisten van de **Europese Verordening voor medische hulpmiddelen EU 2017/745 (MDR)*.
Elke klinische studie met Lumoral heeft duidelijk omschreven doelen en onderzoeksvragen: ofwel ter bevestiging van de werking zoals goedgekeurd bij de markttoelating, ofwel om nieuwe toepassingsmogelijkheden van Lumoral te verkennen.
Strikte naleving van deze regelgeving waarborgt niet alleen de wetenschappelijke integriteit van het onderzoek, maar ook de veiligheid en het welzijn van de deelnemers.
Innovatie als drijvende kracht
Het onderzoek rond Lumoral opent nieuwe perspectieven voor de ontwikkeling van mondzorg. Ons bedrijf is trots om via innovatieve oplossingen bij te dragen aan gezondheid en welzijn.
Zowel lopende als afgeronde studies onderstrepen de veelzijdige toepassingen van Lumoral bij het verbeteren van de mondgezondheid in uiteenlopende doelgroepen en aandoeningen.
Deze wetenschappelijk onderbouwde benadering vormt de kern van onze missie: de mondzorg van morgen vandaag al beschikbaar maken.



Lopende klinische studies
Let op: deze lijst bevat geen eerder gepubliceerde studies.
Gesponsord / door onderzoeker geïnitieerd; Onderzoekers
Aantal beoogde deelnemers (status)
Gesponsord.
Onderzoekers: Saila Pakarinen, Timo Sorsa, Riitta Saarela, Petri Auvinen, Taina Tervahartiala
200 (actief, follow-up)
Gesponsord.
Onderzoekers: Ann-Marie Roos Jansåker, Katja Elses, Vanessa Larsson
40 (actief, follow-up)
Gesponsord.
Onderzoekers: Anna Maria Heikkinen, Kati Ylä-Tuuhonen, Katja Rauhala, Timo Sorsa, Jaana Hagström, Ulla Kotiranta, Taina Tervahartiala, Esko Kankuri
60 (actief, werving)
Gesponsord.
Onderzoekers: Ingrida Pacauskiene, Nomeda Basevičienė, Vita Mačiulskienė, Raimonda Guntulytė, Alma Pranckevičienė, Timo Sorsa, Ismo Räisänen, Petri Auvinen
60 (actief, werving)
Door onderzoeker geïnitieerd.
Onderzoekers: Anna Maria Heikkinen, Millamari Sarja, Satu Kapanen, Teija Raivisto, Timo Kauppila, Ismo Räisänen, Tommi Pätilä, Timo Sorsa, Saila Pakarinen, Essi Teronen, Mikko Kylmänen
120 (actief, werving)
Door onderzoeker geïnitieerd.
Onderzoekers: Nilminie Rathnayake, Timo Sorsa, Akke Kumlien, Monika Kala, Tommi Pätilä
80 (actief, werving)
Door onderzoeker geïnitieerd.
Onderzoekers: Harri Niskanen, Timo Sorsa, Katja Gustafsson, Karim Abdalla, Pekka Kallio
100 (actief, werving)
Door onderzoeker geïnitieerd.
Onderzoekers: Anna Maria Heikkinen, Patrick Saikkonen, Laura Mealonen, Miia Ehrnrooth, Timo Sorsa, Atte Vadén, Andreas Pfuetzner, Marko Helenius, Pirkko Pussinen, Timo Kauppila
150 (actief, werving)
Door onderzoeker geïnitieerd.
Onderzoekers: Paolo Giacomo Arduino, Elio Berutti, Giuseppe Garlo Iorio, Umberto Ricardi, Gugliemo Ramieri, Paolo Garzino Demo, Tommaso Mairano, Alessio Gambino, Giorgia El Haddad
60 (actief, werving)
Door onderzoeker geïnitieerd.
Onderzoekers: Ulla Marjosola, Minna Elomaa-Krapu, Maarit Valtonen, Tommi Pätilä, Pekka Ruuska, Mikko Kylmänen
36 (in ethische beoordeling, geplande start Q1/2025)
Door onderzoeker geïnitieerd.
Onderzoekers: Prof. Alberto De Biase, Prof.ssa Anna Scotto d’Abusco, Dr. Marco Lollobrigida, Dr. Giulia Mazzucchi, Dr. Alessia Mariano
30 (actief, werving)
Door onderzoeker geïnitieerd.
Onderzoekers: Vanessa Faber, Prof. Werner Birglechner
52 (actief, werving)
Gesponsord.
Onderzoekers: Timo Sorsa, Paula Tegelberg, Meeri Ojala, Merja Ylipalosaari, Jori Lindroth, Petri Auvinen
90 (werving voltooid, data-analyse)
Door onderzoeker geïnitieerd.
Onderzoekers: Hellevi Ruokonen, Karita Nylund, Nina-Li Avellan, Patricia Stoor, Kirsten Besuch, Viivi Mattila
80 (actief, werving)
Door onderzoeker geïnitieerd.
Onderzoekers: Elisa Ronkainen, Juho Suojanen, Timo Sorsa, Junnu Leikola, Arja Heliövaara, Taina Tervahartiala
15-20 (werving voltooid, data-analyse)
Door onderzoeker geïnitieerd.
Onderzoekers: Dimitra Sakellari, Chrysoula Vakaki, Veta Doufexi, Timo Sorsa, Ismo Räisänen, Tommi Pätilä
60 (werving voltooid, data-analyse)
Door onderzoeker geïnitieerd.
Onderzoekers: Riina Rünnel, Laura Gusseva, Liisa Lill
30 (werving voltooid, rapportage)
Door onderzoeker geïnitieerd.
Onderzoekers: Riitta Saarela, Timo Sorsa, Saila Pakarinen, Jaana Helenius-Hietala, Wilma Romppainen, Sanna Korte, Tuuli Seitsamo, Taina Tervahartiala
40 (werving voltooid, rapport in peer review)
Door onderzoeker geïnitieerd.
Onderzoekers: Hanna Lähteenmäki, Timo Sorsa, Taina Tervahartiala, Tommi Pätilä, Ismo Räisänen
40 (werving voltooid, rapport in peer review)
In samenwerking met